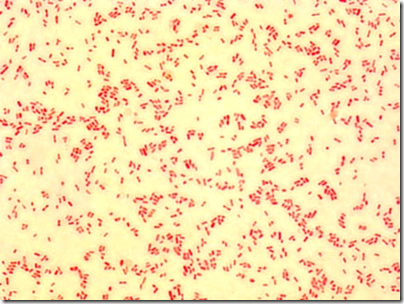
image

Sudah saatnya kita dukung semua karya anak Indonesia gan, terus support mereka. langsung aja ya berikut 12 situs jejaring sosial asli buatan Indonesia


3. Digli.com
DIGLI adalah situs pertemanan dengan rasa Indonesia dimana seluruh pengguna DIGLI bisa berinteraksi satu sama lain sehingga membentuk sebuah aktifitas bersosialisasi.Lebih mudah mendapatkan temanDengan DIGLI, para pengguna bisa lebih mudah mendapatkan teman-teman baru karena di sini para pengguna DIGLI lebih mudah mengakrabkan diri dengan pengguna lainnya. Selain itu, berbagai fasilitas yang tersedia sangat mendukung para penggunanya untuk menjalin komunikasi dengan pengguna-pengguna lainnya,kalau dalam penilaian situs ini menggabungkan antara facebook dengan kaskus.
4. Otofriends.com
Otofriends merupakan sebuah social networking yang baru, diperkenalkan tahun 2008. Situs ini mengusung tema jejaring sosial dengan tagline "Community Gathering, Start From Indonesia". Otofriends dikembangkan oleh mahasiswa asli dari Indonesia, sampai saat saya menulis posting-an ini, saya belum tahu siapa nama pasti mahasiswa tersebut, (pemilik tidak mengespost jati dirinya, hanya menisbahkan diri sebagai Team Otofriends) beberapa forum mengidentifikasinya sebagai mahasiswa Perguruan Tinggi terkemuka di Indonesia. Beberapa user yang telah bergabung, menilai akses Otofriends tergolong cepat dengan fitur komplit serta terus bertambah. Jika dibandingkan dengan Facebook, fitur Otofriends mirip Facebook. Fitur Otofriends dapat dikatakan merupakan kombinasi (gado-gado) dari Facebook, Yahoogroups, Friendster, bahkan Multiply.
5. Lilocity.com

LILO (Little Online) dikembangkan sebagai medium berkumpul anak muda yang berkonsep Virtual World Society (VWS). Sandi Pinatabahri, Manajer Bisnis M-Stars, menyampaikan, "Kami mengembangkan LILO ke arah VWS karena memang kami ingin memberikan tempat untuk anak-anak muda bersosialisasi, berkreasi, dan mengekspresikan dirinya di virtual world."
6. Kongkoow.com

Kongkoow merupakan situs jejaring sosial bercitarasa lokal yang menyediakan fasilitas sangat lengkap seperti akun email, file sharing, video streaming, dan blogging.
7. KenalanYuk.com

kenalan yuk.com adalah situs pertemanan/sosial seperti yang sedang marak dibicarakan saat ini. Fitur-fitur pada KenalanYuk pun agak-agak mirip dengan Facebook. Cuma tentu saja ada perbedaannya. Kalo Facebook > biru maka KenalanYuk > hijau. Silahkan buka sendiri situsnya untuk info lebih lanjut.
8. MyPulau.com

MyPulau adalah situs jejaring sosial yang dimotori oleh pihak telkomsel. Sebenarnya MyPulau sudah ter daftar sejak 28 Agustus 2007. Namun situs yang satu ini, baru aktif baru-baru ini. Namanya juga situs jejaring sosial, disini kamu dapat menemukan serta berkomunikasi dengan teman-teman kamu ataupun mencari teman-teman yang baru. Situs jejaring sosial yang satu ini memiliki kelebihan dimana semua hal yang dimiliki situs jejaring sosial ternama seperti facebook dan twitter ada disini. Bahkan yang ada dalam mypulau.com tidak terdapat pada facebook dan twitter.
9. Koprol.com

Koprol.com merupakan jejaring sosial berdasarkan lokasi yang ditujukan untuk kota – kota di Indonesia, Koprol memberitahu lokasi sesama pengguna Koprol serta menghubungkan sesama penggunanya yang berada ditempat yang sama. Jejaring sosial ini menggunakan metode berbasis lokasi. Disini ponsel pengguna dapat bersifat seperti GPS tanpa aplikasi GPS dari ponsel itu sendiri. Koprol menyediakan sejumlah pilihan tempat dimana penggunanya bisa check-in di lokasi tersebut. Setelah masuk log, di sini pengguna bisa melihat siapa saja anggota lain yang sedang berada di lokasi yang sama.
10. Kidnetmania.com

KID Net yang berarti Kerja Input Data dot Net merupakan produk asli Indonesia, yang membuat wadah bagi anda yang menginginkan pendapatan tambahan melalui internet, ribuan orang sudah bergabung, saat ini sudah masuk 3000-an member lebih. Tugas member kid net adalah sebagai staff data entry dan akan mendapat komisi dari pekerjaan yang dia lakukan. Saat ini KID NET sudah tidak menerima member lagi, kecuali melalui jalur khusus (bayar) dan hanya akan membuka pendaftaran diwaktu-waktu tertentu.
11. Kombes.com

12. Indoface.com